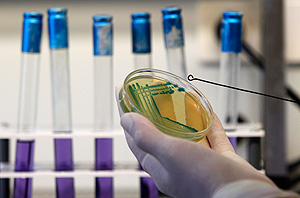
Овощи из ЕС "освободят"

Овощи из ЕС "освободят"
Глава Роспотребнадзора заявил, что пять стран ЕС готовы идти на условия РФ, чтобы возобновить поставки овощей. Образцы штамма уже прошли таможню и готовы к изучению российскими учеными
Москва. 24 июня. INTERFAX.RU - Пять стран ЕС, включая Нидерланды и Польшу, заявили о готовности возобновить поставки свежих овощей в Россию, сообщил глава Роспотребнадзора, главный государственный санитарный врач РФ Геннадий Онищенко. Он отметил, что российская санитарная служба может дать разрешение таможне на ввоз первых партий овощей из ЕС до конца дня. Меж тем, в РФ уже поступили образцы штамма для исследований.
По словам Онищенко, только пять из двадцати восьми стран Евросоюза заявили, что готовы выполнять условия РФ, чтобы возобновить поставку овощей в нашу страну. "Мы на сегодня имеем только заявленные, пока еще нами не разрешенные для провоза страны. В частности, первыми заявились Нидерланды, Польша, Дания, всего пять стран", - сказал он на пресс-конференции в Москве в пятницу. Он отметил, что на данный момент ни одного разрешения не выдано, и форма сертификата не доведена до таможенных органов. Сам сертификат, как сообщалось ранее, предназначен для подтверждения безопасности европейской продукцию. В документе должны быть указаны три параметра: место происхождения продукта, гарантия компетентных органов страны, из которой поставляется продукт, и гарантийное подтверждение того, что продукт не содержит опасной кишечной палочки. Пока форма сертификата не дошла до таможенных служб, никакого незамедлительного и безоговорочного разрешения на ввоз не будет.
В числе пяти стран, которые заявили о готовности возобновить поставки овощей в РФ, глава Роспотребнадзора также назвал Германию и Испанию. "Что вы так за них (европейских производителей) переживаете - вам овощей не хватает? Я могу злоупотребить своим служебным положением, попросить, чтобы вам их выдали посвежее на каком-нибудь рынке, Дорогомиловском", - ответил Онищенко на вопрос одного журналиста о возобновлении поставок овощей из ЕС.
Однако по его словам, это может быть решено "до конца дня". Возможно, соответствующие ориентировки будут даны, как отмечает Онищенко, и белорусской таможне. "Потому, что у нас сейчас Таможенный союз и мы через белорусскую границу пропускаем те грузы, которые идут на Россию. В частности, это овощная продукция", - сказал Онищенко.
Меж тем, сам штамм кишечной палочки, которая вызвала вспышку инфекции в Европе, в пятницу был растаможен и доставлен в российский научный центр в Оболенске. "Мы будем его изучать в ряде институтов нашей страны", - сообщил Онищенко. Ранее штамм был направлен из референс-лаборатории Европейского Союза в Риме и только после был доставлен в научный центр в Оболенске. "Одно дело, когда ты получаешь информацию об инфекции на основании чужих исследований. Другое дело, когда ты сам работаешь с этим штаммом. Это принципиально новая ситуация, она дает нам возможность для собственных научных исследований в плане изучения свойств и разработки мер по профилактике", - отметил он.
Ранее, на пресс-конференции в минувшую среду в Москве после переговоров с ЕС Онищенко сказал, что поставки овощей из Евросоюза могут возобновиться до конца июня. "Не собираюсь гадать на кофейной гуще, но я больших проблем не вижу", - сообщил руководитель Роспотребнадзора. Он сказал на пресс-конференции, что Россия ждет от ЕС список лабораторий, которые будут подтверждать безопасность овощной продукции. "При желании за два-три дня этот вопрос можно решить", - сообщил он. В начале июня Россия ввела временный запрет на ввоз свежих овощей из Европы, причиной стала вспышка кишечной инфекции, зарегистрированная в Европе и прежде всего в Германии.















